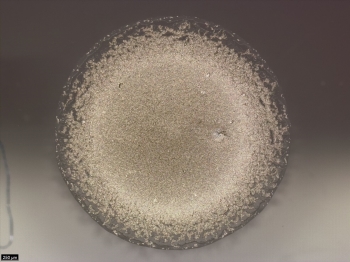
Image

Screen-printing is a well-established technique valued for its ability to process diverse inks, including highly particle-loaded formulations essential several applications in the industrial and graphical industry. However, its reliance on manual labor and limited automation constrains broader adoption. Inkjet printing on the other hand offers on-demand flexibility and scalability but is restricted by its material requirements. Particularly viscosity limitations of around 25 mPa∙s in conventional piezo printheads. Recent advances by Quantica GmbH have introduced a novel printhead technology capable of jetting fluids up to 250 mPa∙s, potentially expanding the range of printable materials. This study investigates the feasibility of adapting highly particle loaded screen-printing inks for use in such high-viscosity inkjet systems. By diluting screen-printing inks with solvents to reduce viscosity, the impact on particle stability, rheological behavior, surface tension, drying dynamics is systematically evaluated. The overall goal is to assess whether particle-rich inks traditionally used in screen-printing can be effectively processed via piezo inkjet technology.

3D printing with current multi-nozzle drop on demand print heads is lacking in terms of surface quality (without post treatment) or printing of overhanging structures without support material in contrast to single nozzle inkjet 3D printing (where the part perimeters are printed with a CNC motion), which in turn is lacking in terms of volume throughput (and therefore only used for the fabrication of small parts) as everything has to be printed with one nozzle. In order to print with enhanced surface quality and overhanging structures - free of support material – as well as reasonable productivity for the production of larger 3D parts, a printing process for industrial multi nozzle printheads with CNC printing motion was developed. First 3D parts printed with paraffin wax were produced and characterized to estimate the potential of this process.

Inkjet printing offers an attractive route for the manufacture of metal oxide films and allows a low-cost, environmentally friendly route to manufacture. Here we describe a stabilised process for the printing of TiO2 films. This has been achieved through the use of a range of titanium (IV) ink solutions, employing stabilised Ti(OiPr)4 or titanium oxo-alkoxide clusters as the source materials. Printed tracks with feature sizes of 156μm have been achieved, along with more complex architectures of TiO2. XRD analyses shows that the as deposited TiO2 is amorphous.